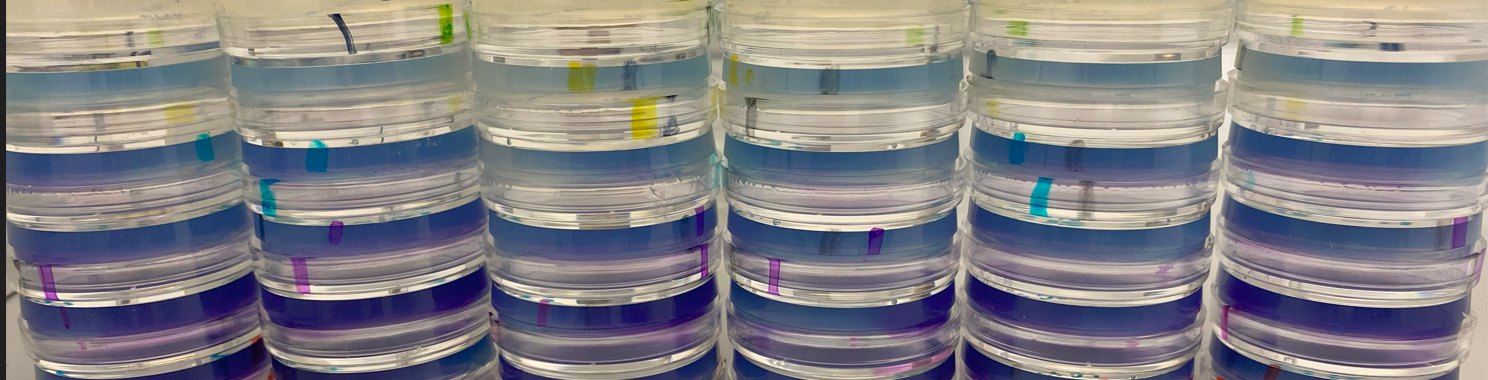

by Buck Institute
July 7, 2023 . BLOG
A Research Associate Has a Colorful Favorite When It Comes to Compound Screenings
We promise, there was no scientific bias in the findings.
 By Theresa FitzGibbon, Research Associate in Lithgow lab
By Theresa FitzGibbon, Research Associate in Lithgow lab
Many chemical compounds are investigated in the Lithgow lab to see if they extend lifespan and healthspan in tiny nematode worms. From my perspective, no compound has been quite as beautiful or interesting as that jack of all trades, the wonderfully dichotomous, purple compound azure blue.
Here’s how I came to that conclusion.
While the Lithgow lab has its own research agenda, we are also members of the Caenorhabditis Intervention Testing Program (CITP). That collaboration dictates my duties as a research assistant.
The CITP screens for compounds that promote healthy aging as indicated by lifespan and healthspan extension in worms belonging to the genus, Caenorhabditis. As a multi-lab effort, the CITP is conducted at three separate lab locations (the Buck, Rutgers and the University of Oregon) allowing replicate studies to be conducted across varying environments. The impact of genetic variance on compound efficacy is addressed by using nine different Caenorhabditis species.
Basically, we take a ton of worms, expose them to different compounds and assess their response. A promising result is called a “hit.” Assessment is done by several CITP technicians across the participating labs…replication…replication!
Daily, I sit at my lab bench, moving hundreds of worms to petri dishes prepared with varying compounds. Sound monotonous? Honestly, it is. Like a kid in need of pictures in a book, things became far more exciting when petri dishes revealed beautiful shades of purple after being prepped with azure blue.
Azure blue found its way to the CITP from a higher throughput screening method developed by me and another technician, David Hall. David really is the engineer behind the operation. Unabashedly, I am more of a robot that helps ensure screening is complete.
After screening for azure blue I reviewed the hits. My excitement over the color was amplified after reading about the compound’s applications. I’ve become an annoyingly enthusiastic cheerleader for this compound, and its parent methylene blue (MB). Initially, I worried that with a “pom-pom” in hand I might unintentionally skew data. But again, the CITP hangs its hat on replicate assays, so I think any bias on my part is not an issue.
Here's the scoop on azure blue: It is derived from MB which is often used for hematological staining. Unstable, MB breaks down into colored metabolites, one of which is azure blue. Beyond staining, MB has been used as an antimalarial and is FDA approved for the treatment of a rare blood disorder called methemoglobinemia and cyanide poisoning. Efficacy has been shown for septic shock, hepatopulmonary syndrome, reversal of toxicity following Ifosfamide chemotherapy and disruption of Lumpy Skin disease, a not so cryptic name given to a cow disease. Research even shows efficacy in regard to COVID treatment.
Concerning aging, MB is currently in a phase III clinical trial for effects on cognitive function in Alzheimer's patients. Prior research indicates MB’s inhibitory effects on two enzymes, cholinesterase and caspase as well as inflammatory cytokine production. A decrease in Aβ production, (implicated in Alzheimer’s) and enhancement of proteostasis, a process that keeps our proteins happy, were indicated in mouse studies.
Certain cosmetic companies incorporate MB into skin care products. Let’s just hope they keep MB to low doses since blue skin can be a side effect at high concentrations!
After reading the laundry list of MB applications I couldn't resist doing a small lifespan assay irrespective of the CITP.
I assessed the lifespan of C. elegans on five different concentrations of azure blue (clarification: the compound is blue, but only at lower doses). After a few days it became apparent, the worms exposed to azure blue looked fit and appealingly purple. Understanding my heartfelt leanings for this molecule, I made sure to have others in the lab take a look. They agreed, it was night and day, the intervention was indeed intervening.
While most literature pertains to MB, the lifespan assay, and results from other testing David decided to carry out, suggests that the apple might not fall far from the tree. We have decided to move forward with “CITP approved” azure blue testing. Now I can only hope that the answer to living better longer turns us all purple.
SHARE